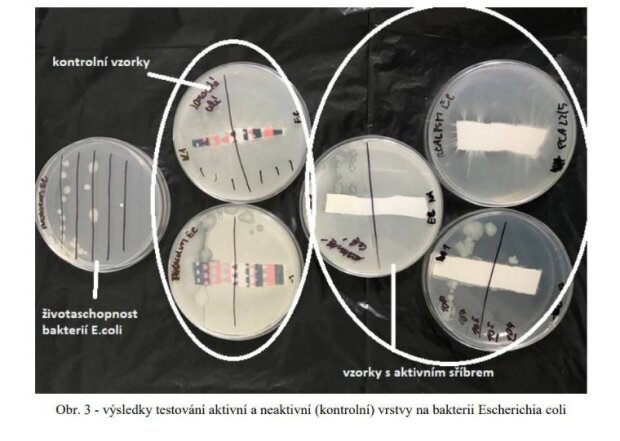
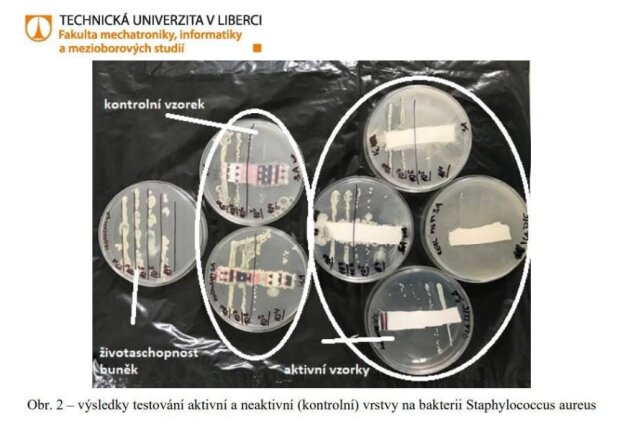

Čechům během pandemie koronaviru a několikrát se prostřednictvím sociálních sítích nechala slyšet, že její roušky jsou s aktivním stříbrem, a dokonce jsou stejně účinné jako respirátory FFP3.
Dle svých slov Nela Slováková v dobré víře pomoci Čechům, kteří se na začátku koronavirové krize potýkali s nedostatkem roušek a dezinfekčních gelů.

Nela však slibovala hory doly a lidem na sociálních sítích tvrdila, že nedostatkové zboží nakupuje po tisících.
V sociálním protokolu se píše, že podle výsledků je patrné, že ani kontrolní, ani látka s aktivním stříbrem nevykazovala rozdíl, a tudíž nebyla prokázána její antibakteriálnost.

Z tohoto lze usuzovat, že textilie s aktivním stříbrem neobsahovala žádné částice stříbra nebo tyto částice nebyly pevně vázány na textilii a již se v aktivní vrstvě nevyskytovaly.

Nela ze své strany pověděla, že roušky a vše kolem vyšetřuje Policie České republiky a Česká obchodní inspekce, není to nic, co by nebyla pravda.

Bohužel opět bude muset využít právní pomoci ke kontaktování univerzity v Liberci, aby vyjasnila své vyjádření, které je krajně zavádějící.
Tereza Brodská z nemocnice nechala fanouškům jasný vzkaz: "Jsem ráda, že to mám za sebou"
Herečka Ha Thanh Špetlíková promluvila o své touze adoptovat dítě: "Už si netroufám nic plánovat, ale je to moje přání"
Téměř lidská tvář: jak pes s neobvyklou tváří stal slavným po celém světě
Modelingová kariéra dívky, na které matka vydělala peníze, skončila skandálem
Na videu Nela také dodala: “Prosím vás, nenaleťte nikomu, kdo se vám bude snažit prodat obyčejnou textilní roušku. Taková rouška vám je k ničemu”.
“Zjišťovala jsem veškeré certifikáty a náležitosti, které ty roušky musí obsahovat a roušky typu FFP3, která je dostačující, tak stejně tak je dostačující rouška s aktivním stříbrem, to jsou naše roušky nebo s uhlíkem či nanomateriálem”.
Zdroj:extra.cz
Dříve jsme psali: JE TĚŽKÉ TOMU UVĚŘIT: VZÁCNÁ DVOJČATA ZAPŮSOBILA NA VŠECH SVÝM VZHLEDEM
Připomínáme: "KVŮLI GENETICKÉ VLASTNOSTI MUSÍM ŽÍT JAKO UPÍR"





































